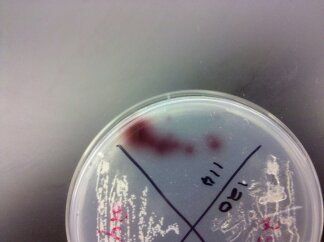
DroidPictures236.jpg

I'm moving into the field of law, because growing up as I did caused me a great deal of pain. Everyday of my life I've seen unjust things, and I've been affected by them. I want to make a difference, whether it be through political or just by being a law enforcement officer. Every step of the way in my life I've seen sexism,racism, and prejudice. I want to try to change that. I'm tired of some people being treated as privileged due to their gender, or their race.
We've solved so many problems in this country, and in this world, but we can't get past some simple things. The day this all changed, and I decided that I really wanted to help other people was the day I watched a woman walk into a room full of people who were relaxing, and enjoying their time.. She walks up to this man sitting against the wall, minding his own buisness and talking about his pets to the man next to him. She walks up to him and starts screaming at him in unintelligible english, he only stares at her in confusion.... This woman, half his size now grabs him by his hair and starts repeatedly beating him in the face.... He is only attempting to push her off of him. She eventually drags him to the middle of the room and is repeatedly slapping and punching him in the face, holding his head down by his hair. He finally shoves her away from him, with just enough strength that she lets go of him and stumbles a bit. He only says one word and he says it in desperation, He says "Stop." She attempts to go at him again, at this point another woman steps in and keeps her from reaching him. This woman now screams at the man and says "Leave! Get out! How dare you!" It's not to the woman she says this, but to the man.... He looks at her in shock, he can't believe what he's heard, and I myself a few feet away having witnessed all of this, mouth agape, can't either. He doesn't argue, he doesn't say a word, he retrieves his stuff from the wall he was just at, and leaves quietly.... And then the woman and more than a few in the room start to comfort the girl... The man left because he knew he couldn't say anything, society wouldn't permit it. He was a man, and she a woman... No matter what he say, she was somehow in the right even though any person who could think could easily see that this man was the victim.... But no, because he was in fact Man. He was the aggressor.
I don't want to ever see something like that happen again. And I want to be able to legally help in instances of sexism or racism... That's why I'm going into Law.